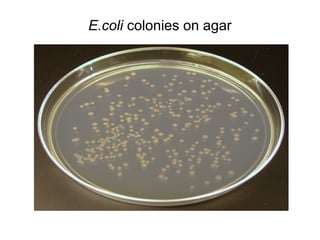
E.coli colonies on agar
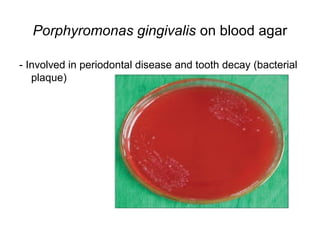
Porphyromonas gingivalis on blood agar 
- Involved in periodontal disease and tooth decay (bacterial 
plaque)
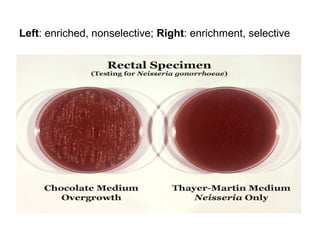
Left: enriched, nonselective; Right: enrichment, selective

This document discusses various methods used in clinical microbiology for the diagnosis of bacterial infections, including specimen collection, microscopy, and bacterial culture. It emphasizes the importance of proper specimen collection for accurate diagnosis, describing rules for collecting samples from the correct site and in optimal quantities while avoiding contamination. Microscopy techniques described include staining methods like Gram stain, Ziehl-Neelsen stain, and Giemsa stain to identify bacteria, mycobacteria, and parasites under an optical microscope. Bacterial culture methods involve using various liquid and solid growth media suited to different microbial needs to isolate and identify infectious agents.